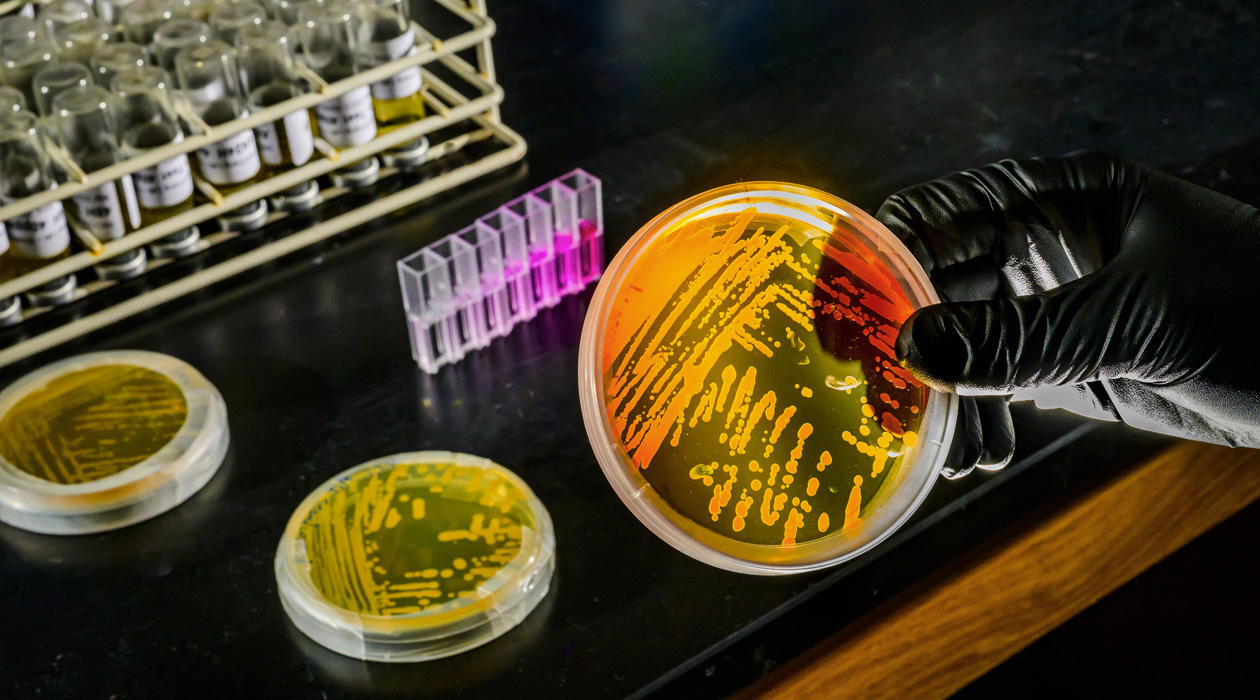
A research group co-led by the University of Illinois Urbana-Champaign predicts that a surprisingly adaptable species of marine archaea will play an important role in reshaping biodiversity in the planet’s oceans as the climate changes. Photo by Fred Zwicky

New study finds deep ocean microbes already prepared to tackle climate change
A research group co-led by the University of Illinois Urbana-Champaign predicts that a surprisingly adaptable species of marine archaea will play an important role in reshaping biodiversity in the planet’s oceans as the climate changes. / Fred Zwicky
Deep-sea waters are warming due to heat waves and climate change, and it could spell trouble for the oceans’ delicate chemical and biological balance. A new study, however, demonstrates that the microbe Nitrosopumilus maritimus may already be adapting well to warmer, nutrient-poor waters. Researchers predict that these surprisingly adaptable iron-dependent ammonia-oxidizing archaea will play an important role in reshaping ocean-nutrient distribution in a changing climate.
The study’s findings are published in the Proceedings of the National Academy of Sciences.
Nitrosopumilus maritimus and its kin account for approximately 30% of the marine microbial plankton population, and many researchers agree that the oceans depend on these microbes to drive the chemical reactions that support marine life. The ammonia-oxidizing activity of archaea makes them key players in the oceans’ nutrient cycling. By altering the forms of nitrogen available in seawater, they control the growth of microbial plankton — the base of the marine food chain — and help sustain marine biodiversity.
“Ocean-warming effects may extend to depths of 1,000 meters or more,” said University of Illinois Urbana-Champaign microbiology professor Wei Qin (IGOH). “We used to think that deeper waters were mostly insulated from surface warming, but now it is becoming clear that deep-sea warming can change how these abundant archaea use iron — a metal they depend on heavily — potentially affecting trace metal availability in the deep ocean.”
The study, led by Qin and University of Southern California global change biology professor David Hutchins, used controlled, trace-metal-clean experiments to expose a pure culture of Nitrosopumilus maritimus to a variety of temperatures and iron concentrations. They observed that increasing the temperature under iron-limited conditions reduced the microbes’ iron requirements and increased physiological iron-use efficiency, demonstrating that the microbes acclimate well to the stress of higher temperatures and decreased iron availability.
“We coupled these findings with global ocean biogeochemical modeling by Alessandro Tagliabue from the University of Liverpool,” Qin said. “The results suggest that deep-ocean archaeal communities may maintain or even enhance their role in nitrogen cycling and primary production support across vast iron-limited regions in a warming climate.”
This summer, Qin and Hutchins will serve as co-chief scientists aboard the research vessel Sikuliaq for a research expedition from Seattle to the Gulf of Alaska and then down to the subtropical gyre, stopping in Honolulu, Hawaii. Joining Qin will be 20 other researchers whose aim will be to validate the new experimental findings in a real-world setting and focus on the interactive effects of temperature and metal limitation on natural archaeal populations.
The National Science Foundation, Simons Foundation, National Natural Science Foundation of China, University of Illinois Urbana-Champaign and the University of Oklahoma supported this research.
***
The paper “Ocean warming enhances iron use efficiencies of marine ammonia-oxidizing archaea” is available online. DOI: 10.1073/pnas.2531032123
